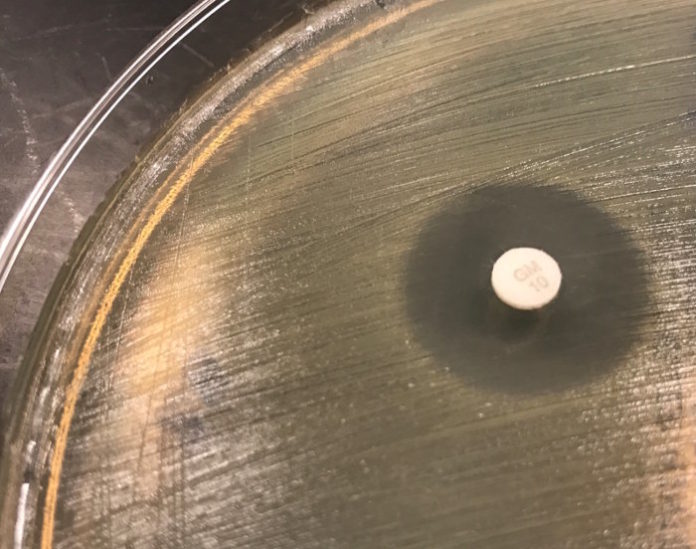

In the era of relentlessly increasing antimicrobial resistance, a newly introduced antibiotic is greeted by clinicians not as the latest addition to a rich armamentarium for the fight against infectious diseases (as, for example, tetracycline or vancomycin might have been in the 1950s) but as a desperately needed therapy of last resort for patients infected with organisms against which most, if not all, currently available antibiotics are impotent. The urgent need for new broad-spectrum antibiotics is reflected in government initiatives, such as the Generating Antibiotic Incentives Now (GAIN) provisions, which incentivize the development of new antibiotics and expedite their review process. Even so, clinicians often utilize the compassionate use process to access an antibiotic that is still in investigational status for critically ill patients with few remaining therapeutic options.
As eager as clinicians are to provide a new antibiotic to a patient who may benefit from it, they first want to know whether it will be effective against the particular organism infecting the patient. As they are accustomed to doing, they turn to the clinical microbiology laboratory to provide antimicrobial susceptibility testing (AST) results, but here they are frequently met with a very unpleasant surprise: AST is not yet available for the new antibiotic.
The AST development process
What exactly has to happen before commercial AST for a new antibiotic is introduced, and why does it take so long? First, a test must be developed by an AST manufacturer. While in theory this process can begin while a drug is still until in investigational status, in practice manufacturers often wait until it appears that FDA approval is likely. Furthermore, AST clinical trials can only include pathogens for which a drug has a specific FDA-approved clinical indication, but these indications are not known until the antibiotic’s New Drug Application (NDA) is approved. Once the test is developed,it must be approved by the FDA, and even after it receives FDA clearance it must undergo in-house verification in any clinical laboratory that adopts it, in order to demonstrate that it performs as expected when used by that laboratory.
For single-agent AST tests, such as antimicrobial susceptibility disks or gradient diffusion test strips, development may be fairly straightforward. However, most commercial minimal inhibitory concentration (MIC) test panels have limited physical space for the addition of new antibiotics and can only add wells for a new antibiotic at the expense of antibiotics already in the panel. Similarly, addition of new antibiotics to automated AST test cards requires the introduction of an entirely new card, and for systems such as the VITEK® 2, which use calculated rather than direct MIC measurements, the development process may quite involved. As a result, there is often a significant delay before manufacturers determine the best way to integrate the new drug into their testing platforms.
Once a new test is developed and cleared by the FDA, a process which may take 1-5 years, each laboratory that adopts it must perform a verification before using the test on patient samples. Guidelines for verification of FDA-approved tests are laid out in CLSI’s M52 document. If a lab already routinely performs disk diffusion testing, they can test as few as 5 isolates to verify a disk for a new antibiotic, although for other test methods the process may involve testing 30 or more isolates with a range of MICs. The difficulty arises in acquiring isolates for which the true MIC is known: since the lab has no established method for performing AST for the new antibiotic, it has no way to establish a comparator MIC. This introduces a circular dilemma: the lab must verify a new test against a verified test, but it can only acquire a verified test by verifying that test against… a verified test.
There are a few options available to address this problem. The FDA-CDC Antimicrobial Resistance Isolate Bank offers isolates with a range of resistance profiles and known MICs, including strains resistant to recently introduced antibiotics. Another approach is to send clinical isolates that are submitted to the laboratory to a reference laboratory to determine their MICs. As discussed below, this is frequently also how labs obtain clinical AST results before they are able to perform testing in-house. If they save isolates that were sent out for AST and record the MIC results obtained by the reference laboratory, they will gradually acquire a collection of isolates with known MICs, which they can use for an AST verification study. However, the collection of a sufficient number of such isolates takes time, particularly as costly new antibiotics are often used infrequently in the first months or years after their introduction.
What is a lab to do?
The result of the complex process of AST development is a delay (which may last as long as several years) between the introduction of a new antibiotic and completion of in-house verification of commercial, FDA-approved AST for that antibiotic. Clinicians, however, cannot wait several years after an antibiotic’s introduction before they start using it. How, then, can a clinical laboratory provide them with useful information in the interim? There are several possibilities, outlined below.
Laboratory-developed AST
The first option, in-house development and validation of a reference method, such as broth microdilution, or a laboratory-developed test (LDT), may be conceptually the most obvious, but it is often prohibitively difficult to carry out in practice. However, standard dilution testing (broth microdilution or agar dilution) is highly labor-intensive, and most clinical laboratories simply do not have the resources or experience with relevant methods required to develop and perform such tests in a clinically relevant timeframe. Furthermore, obtaining antibiotic powder from a drug manufacturer to prepare these tests is a complex and lengthy process in the first years of a new drug’s availability. Some laboratories may develop LDTs with research-use only (RUO) susceptibility disks or gradient test strips that are made available by the drug manufacturer soon after the drug’s approval. Because the FDA does not allow RUO reagents to be used for patient testing, however, t, laboratories cannot officially report the results of such tests in the clinical record. Regardless of the method used, the development and validation of a reference method or LDT requires testing an even larger number of isolates than are needed for verification of an FDA-approved test, which makes development of AST for the newest antibiotics challenging.
Reference Laboratory AST
Perhaps the most common approach to AST for new antibiotics is to send isolates to a reference laboratory. Unlike most clinical laboratories, reference microbiology laboratories have the capacity to readily develop and validate broth microdilution or agar dilution tests. Nevertheless, there is still usually some delay before the largest reference laboratories begin to offer AST for new antibiotics, and AST may at first be available only at a specialty lab (e.g. Laboratory Specialists, Inc.), often through a program affiliated with the drug manufacturer. In some such cases the drug manufacturer may place restrictions on which isolates can be tested; for example, AST offered through this type of program for ceftolozane/tazobactam, was provided only for isolates obtained from body sites corresponding to the drug’s FDA-approved indications (i.e. urinary and intra-abdominal isolates). The main downside of reference laboratory AST is the delayed availability of results.
Surrogate susceptibility testing
In some cases, new antibiotics are introduced that are closely related to existing antibiotics in the same class. In these cases, susceptibility to the new agent may be predictable based on susceptibility to a related antibiotic for which AST is readily available. This is the case for the lipoglycopeptides: telavancin, dalbavancin, and oritavancin. AST options are very limited for these drugs, even at reference laboratories, but susceptibility to vancomycin is highly predictive of susceptibility to the lipoglycopeptides. The studies linked above also noted that lipoglycopeptide resistance in Staphylococcus aureus (the most common organism for which these drugs are used), is extremely rare, as it is for vancomycin, although this is not the case for Enterococcus species. In another example, susceptibility or resistance to linezolid is predictive in the majority of cases of susceptibility or resistance to tedizolid, an oxazolidinone antibiotic introduced in 2014. It should be noted that such surrogate testing is not appropriate for drugs with primarily Gram-negative activity like ceftazidime-avibactam and ceftolozane-tazobactam, which are specifically introduced to overcome existing resistance mechanisms.
AST Future Directions
Clinicians are often confused and frustrated when they learn that their lab can’t immediately perform AST for a newly introduced antibiotic. There are many reasons for the delay between the introduction of a new antibiotic and the availability of AST for that antibiotic, as described above, but the implications for patients of this delay in AST availability are significant. Fortunately, many of the stakeholders in AST development and use are increasingly recognizing the importance of accelerating AST development. In September 2016, the FDA held a workshop on coordination of development of antimicrobials and AST, and CLSI’s Subcommittee on AST frequently addresses these issues and publishes a newsletter through the AST Outreach Working Group to disseminate relevant updates to laboratories. Resources such as the FDA-CDC Antimicrobial Resistance Isolate Bank are also making the process of validating and verifying AST for new antibiotics more practical. It will be essential for all concerned parties–including pharmaceutical companies, AST manufacturers, government agencies, and clinical microbiology laboratories–to continue to prioritize rapid development and adoption of AST for new antibiotics a critical component in the fight against drug resistance.
The above post reflects the thoughts of its author, Dr. Thea Brennan-Krohn, and not the American Society for Microbiology.
Source: ASM